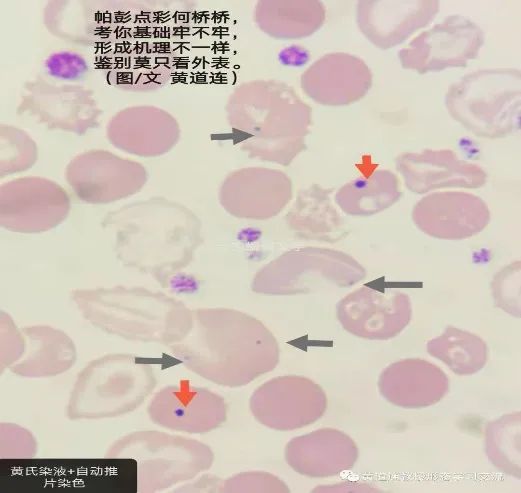
血小板低可以补硒吗（补血小板低硒可以吗）-硒宝网

血小板低可以补硒吗(补血小板低硒可以吗)
血小板减少吃什么食物补的快?
患者信息:男 72岁 病情描述(发病时间、主要症状等):慢性白血病,化疗后白细胞109,血小板,30多,想得到怎样的帮助:吃什么补,花生红衣和鲫鱼汤好吗?我想请问下花生红衣什么样子的最好,生花生的红衣还是炒熟的红衣,
1.患者应多食用富含高蛋白的食物,如牛奶、瘦肉、鱼类、蛋类、豆类等食品。
2.中医认为血热则妄行,出血属热者,适宜选用性偏寒凉食物。蔬菜水果中性凉者,多对止血有利,可在饮食配餐中应用,尤其是荸荠、莲藕、荠菜、黑木耳、梨、鲜枣等更佳。
3.同时伴有贫血的患者,宜在饮食中进食含铁丰富的食物,如动物肝、猪肚、禽类肫、瘦肉、蛋黄等。蔬菜中含铁量较高的马兰头、油菜、荠菜、芹菜、大头菜、黄花菜、苋菜、菠菜、番茄等食物可经常食用。面筋、麦麸、银耳、蘑菇、香菇等也可在烹饪菜肴中应用。
4.血小板减少症患者在出血少而渐停时,食疗中宜以健脾、益气、摄血为原则,应选择药食妙品红枣、花生(带农)配制成药膳、菜肴,也可以每日适量嚼食。无花果、葡萄干,也可经常食用。
5.久病气虚、神疲乏力的患者,食疗中还??捎没栖?、红枣、山药、花生米、枸杞子、桂圆肉、党参、藕节、旱莲草、仙鹤草、羊骨、花生衣、黑豆、猪肤、扁豆、核桃仁等药食佳品煲粥、煨汤或煎汁食服。对老年血小板减少性紫癜尤为适宜。
血小板减少的病人在饮食上要保证各种营养成分的供给,宜多食富含优质蛋白质、多种维生素和含微量元素铁较多的蛋类、牛奶、豆类、新鲜、蔬菜和水果、海产品等。食疗原则以补气养血,滋阴凉血、止血为主。
血小板减少分成三种,饮食也有所不同。
实热型:
饮食宜清凉之品,可以进食绿豆汤、兔肉、田螺、香蕉、甘蔗、橄榄、藕、冬瓜、丝瓜、空心菜、黄花菜、茭白等清解毒热之物,忌食或少食羊肉、狗肉、牛肉、鸡肉、驴肉、雀肉、水龟肉、胖头鱼、黄花鱼、荔枝、杨梅、核桃仁、杏、辣椒、花椒、胡椒、蒿子杆、大蒜、芥菜、榨菜、丁香、茴香菜等性温、辛热之品,以避免发生紫斑连片,使毒热更盛。
虚热型:

饮食宜凉润之品,可以进食菠萝蜜、柿子、丝瓜、菠菜、空心菜、藕、蚌、银耳、木耳、猫肉、青鱼、黑鱼、鳖、干贝、河蟹、水龟肉、银鱼、鸭肉等滋阴凉血之物,以辅助治疗。忌服或慎用温散、燥热、助阳之品,以避免发生出血量多,及心烦急躁、不得安宁等虚热迫扰之证。
通过食物可以加快血液的形成,达到补充血液的效果,如花生衣、阿胶枣都可以的。
血小板减少若低于5万下最好是治疗下,避免给身体造成其他的伤害,预防血流不止的威胁。血小板减少可以使用中医治疗,可以渗透力强,能迅速进入细胞、血液、皮肤、内脏等组织器官的病灶部位,活血散瘀、清解血毒、调理脏腑“卷柏紫癜方”等中药在使用中都不错。另外补助以饮食调理可以更快的恢复身体健康:
1、白茅根藕节煎:取鲜白茅根60克,鲜藕节60克。将白茅根挖采后洗净,切段。将鲜藕挖采后,切下藕节,洗净,切片,与白茅根同人锅中,加水适量,煎煮30分钟,去渣取汁。上下午分服。有清热凉血,收敛止血功效。2生米炖红枣:取花生衣30克,红枣20枚。将红枣洗净,与花生衣同人锅中,加水适量,小火煨炖30分钟,即成。上下午分服,饮汤,吃花生衣,嚼食红枣。具有补气摄血功效
以上是对“血小板减少吃什么食物补的快”这个问题的建议,希望对您有帮助,祝您健康!
病情分析:有些患者化疗的副作用是很大的,有些的副作用是很小的,建议补硒辅助治疗,如硒维康口嚼片。 研究显示,在化疗前后服用较大剂量硒,可以减少白细胞降低,恶心、呕吐、食欲减退、严重脱发、肾毒性等副作用,从而有助于合理加大化疗药物的剂量,以取得更好疗效。
意见建议:建议你化疗期间的饮食:1少吃多餐让病人想吃就吃注意食物的色香味形.2多酸甜少苦辣放化疗病人对甜味和酸味的感觉弱对苦味较为敏感所以应该适当增强酸甜食物.3日常饮食宜清淡注意上面“多酸甜”是适当多吃酸甜的食物而不是吃太酸甜的东西尤其不要给病人吃太甜的食物.另外做菜时要尽量根据患者对咸淡的感觉调节食盐的用量.4适当口服小分子的营养品.由于放化疗病人肠道消化能力一般吃得很营养也未必能被肠道吸收所以适当口服小分子营养更适合放化疗病人.
白细胞减少症患者多属中医虚证或虚劳范畴,故当忌食下列食品:
1.柿子:大凉之果,极易损伤脾胃阳气,凡白细胞减少者,慎勿服之。
2.荸荠:性寒,破积耗气之品,体弱之人白细胞减少者,忌食之。白细胞减少的虚劳之人,切勿多食。
3.槟榔:为破气伤正之果。体质虚弱的白细胞减少者,切勿服食。
4.薄荷:辛凉之品,疏风散热,只泻不补。故凡虚弱之病,包括白细胞减少症者,皆当忌食。
5.芥菜:又称雪里蕻,民间多视之为发物,有耗气伤正之弊故体弱者白细胞减少之人,不宜多食。
此外,白细胞减少症者还应忌食生萝卜、萝卜缨、地骷髅、苦瓜、金橘等耗气伤正之品;也忌食胡椒、辣椒、桂皮、食茱萸、草豆蔻、荜澄茄等辛辣温燥伤阴的刺激性食物;还忌食生瓜、茼蒿、香蕉、螃蟹、蚌肉、田螺等寒凉损阳、生冷伤脾食品。
以上是对“血小板减少吃什么食物补的快”这个问题的建议,希望对您有帮助,祝您健康!
显示全部答案>>
病情分析: 你好,贫血的类型很多的,最简单的办法就是去查查血常规,另外从你的症状来看并不能绝对就是贫血的问题,还有可能与脑供血不足以及颈椎病都有关系.
意见建议:你的情况最好是食疗,饮食营养要合理,食物必须多样化,食谱要广,不应偏食,否则会因某种营养素的缺乏而引起贫血.要富有营养及易于消化.饮食应有规律,有节制,严禁暴饮暴食.多食含铁丰富的食物,如猪肝,猪血,瘦肉,奶制品,豆类,大米,苹果,绿叶蔬菜等.多饮茶能补充叶酸,维生素B12,有利于巨细胞性贫血的治疗.但缺铁性贫血则不宜饮茶,因为饮茶不利于人体对铁剂的吸收.适当补充酸性食物则有利于铁剂的吸收.忌食辛辣,生冷不易消化的食物.平时可配合滋补食疗以补养身体.祝早日康复
你好!白细胞低的病人首选饮食上要给予充分的营养支持,要多食一些有助提升免疫的食物,诸如薏米,甲鱼,山药等,也需多食一些有助提升白细胞的食物,如蜂王蜜,羊骨髓,蘑菇,人参,大枣等都是很不错的。
指导意见:
白细胞的正常值是4-10,如白细胞低于4,要及时进行升白治疗,可以在医师的指导下口服利血生,鲨肝醇,以及维生素B4等食物,治疗期间建议患者加以服用硒维康口嚼片补硒,提升患者的血硒含量,硒能够直接参与机体的代谢,有效的调节患者的免疫,维持白细胞稳定在4000以上,白细胞的提升对增强自身的抵抗力有决定性的作用。
以上是对“血小板减少吃什么食物补的快”这个问题的建议,希望对您有帮助,祝您健康!
病情分析: 引起血小板减少的原因的太多了,例如骨髓生成血小板不足、白血病、再生障碍性贫血、阵发性睡眠性血红蛋白尿、酗酒、巨幼细胞贫血、某些骨髓疾病等,所以要去医院先检查清楚病因,才可以对因治疗。
意见建议:食物中可食用花生衣、大枣、桂园,对提升血小板有一定帮助,另外需忌辛辣刺激性食物、海鲜羊肉等,以免诱发出血。在饮食上要保证各种营养成分的供给,宜多食富含优质蛋白质、多种维生素和含微量元素铁较多的蛋类、牛奶、豆类、新鲜、蔬菜和水果、海产品等。食疗原则以补气养血,滋阴凉血、止血为主。
病情分析: 你好, 建议先去检查一下,什么原因引起的血小板减少;如花生衣糖浆,维生素C和路丁。三个都是增加血小板的药, 有一种“偏方”,即“三红”——红糖、红枣、红皮花生,一起熬汤喝,又甜,而且升血效果不错。
意见建议:在日常饮食中应该增加营养,多食鸡,鸭,鱼,肉,牛奶和豆制品等.选择含铁较多食品如动物的肝脏,肾脏,心脏,瘦肉,蛋黄.蔬菜以波菜,芹菜,番茄.水果中以杏,桃,李,葡萄干,红枣,波罗,无花果等.还可以选用炖乌鸡,花生等补血.以养正气!!
你好, 建议先去检查一下,什么原因引起的血小板减少;如花生衣糖浆,维生素C和路丁。三个都是增加血小板的药, 有一种“偏方”,即“三红”——红糖、红枣、红皮花生,一起熬汤喝,又甜,而且升血效果不错。
意见建议:在日常饮食中应该增加营养,多食鸡,鸭,鱼,肉,牛奶和豆制品等.选择含铁较多食品如动物的肝脏,肾脏,心脏,瘦肉,蛋黄.蔬菜以波菜,芹菜,番茄.水果中以杏,桃,李,葡萄干,红枣,波罗,无花果等.还可以选用炖乌鸡,花生等补血.以养正气!!
你好, 建议先去检查一下,什么原因引起的血小板减少;如花生衣糖浆,维生素C和路丁。三个都是增加血小板的药, 有一种“偏方”,即“三红”——红糖、红枣、红皮花生,一起熬汤喝,又甜,而且升血效果不错。
意见建议:在日常饮食中应该增加营养,多食鸡,鸭,鱼,肉,牛奶和豆制品等.选择含铁较多食品如动物的肝脏,肾脏,心脏,瘦肉,蛋黄.蔬菜以波菜,芹菜,番茄.水果中以杏,桃,李,葡萄干,红枣,波罗,无花果等.还可以选用炖乌鸡,花生等补血.以养正气!!

病情分析:
大枣:有补脾、益气、养血的功效,凡血虚、贫血、血小板减少、白细胞减少者,均宜食用。对肿瘤病人经放疗或化疗后引起白细胞减少者,民间习惯用红枣同赤小豆、糯米煮粥服食。
指导意见:
蜂王浆:具有滋补、强壮、健脾的功效,尤其适宜癌症病人治疗后白细胞减少者食用。有报道说:一位70多岁的老妇胡某,因乳房癌,后又发生肺癌,年高体弱,白细胞仅1000/毫升,既不能手术,又不能化疗,老人只得试服鲜蜂王浆,10多天后,白细胞升至5000/毫升。
病情分析: 常见的是缺铁性贫血,可以吃些富含铁剂 的食物,动物肝脏,大枣等
意见建议:男人大多是缺铁性贫血的,这个是由于体内的铁缺乏,铁质是合成血红蛋白的主要原料,及时补充,是可以纠正贫血的状况的。建议可以用铁剂和食疗的方法来纠正和调理的。铁剂方面可以吃一两个月的铁之缘片,这个不仅补铁还含有阿胶补血气,吸收好,平时在多吃点含铁质高的食物比如猪血,猪肝,黑色的食品比如黑芝麻,黑豆,黑木耳等。另外可以买点阿胶,每次取一块,隔水蒸化后。
以上是对“血小板减少吃什么食物补的快”这个问题的建议,希望对您有帮助,祝您健康!
问题分析:血小板减少;可以吃花生衣糖浆,维生素C和路丁。三个都是增加血小板的药, 有一种“偏方”,即“三红”——红糖、红枣、红皮花生,一起熬汤喝,又甜,而且升血效果不错。
意见建议:在日常饮食中应该增加营养,多食鸡,鸭,鱼,肉,牛奶和豆制品等.选择含铁较多食品如动物的肝脏,肾脏,心脏,瘦肉,蛋黄.蔬菜以波菜,芹菜,番茄.水果中以杏,桃,李,葡萄干,红枣,波罗,无花果等.还可以选用炖乌鸡,花生等补血.以养正气!!
血小板低有两种情况:一种叫原发性的血小板降低,另一种叫继发性的血小板降低。如果是继发性的,要治疗引起血小板降低的原发病。如果是原发性的,我们也称为特发性,它往往是免疫功能异常引起的,主要进行免疫治疗。

一般来说,血小板降低的情况下可以用些升血小板的药,如花生衣糖浆,又称宁血糖浆。当然也可以服用些中药,维生素C和路丁也是我们通常用的.
以上是对“血小板减少吃什么食物补的快”这个问题的建议,希望对您有帮助,祝您健康!
病情分析: 您好,贫血包括缺铁性贫血,营养性巨幼细胞性贫血,溶血性贫血等等,最常见的为缺铁性贫血,主要是由于机体铁摄入不足或者丢失过多等因素导致。
意见建议:建议您到正规医院进行详细检查,明确贫血的类型,如果为缺铁性贫血那么平时可食用含铁量丰富的食物如动物肝脏,动物血,海带,紫菜等,可口服铁剂如富马酸亚铁,硫酸亚铁及维生素C补充铁蛋白
羊脊骨汤羊脊骨(连尾)1条,肉苁蓉10g,菟丝子10g,葱、姜、盐适量。将羊脊骨碎成块;肉苁蓉酒浸一夜,刮去粗皮;菟丝子酒浸3日晒干,捣末,用水适量,放入羊脊与苁蓉,同炖至熟透,调入菟丝子末及调味品。此为1日量,分2次空腹食之。该药膳有补肾阳、益精血、健脾胃的功效。适用于肾精不足型血小板减少性紫癜
首先应仔细查找引起粒细胞减少的原因,根据病因选择相应的治疗措施。如因药物引起者,应立即停药。促白细胞生成药物临床应用种类较多,但疗效均难以确定。如维生素B6、利血生可用于各种粒细胞减少症。维生素B4、鲨肝醇、肌苷、脱氧核苷酸、康力龙等对抗癌药、放疗或氯霉素等因素所致的白细胞减少有较好疗效。
病情分析:你好,血小板减少的原因很多,按其发病原因可分为原发性和继发性两种,需要首先针对病因进行治疗,
指导意见:临床上主要是用激素,严重者可以考虑作脾切除。另外还可考虑使用免疫抑制剂、免疫球蛋白、达那唑、输注血小板、血浆置换、促血小板生成药以及中医中药。单纯的依靠食物可能没有太大的作用的。
以上是对“血小板减少吃什么食物补的快”这个问题的建议,希望对您有帮助,祝您健康!
西医治疗首选激素,一般都可以起到一定的缓解病情的作用,但是达不到治本,而且激素长期使用对身体副作用很大,随着激素的减量或是停用,血小板还是会下降的.
这种疾病食疗可以起到铺助作用,达不到治疗的效果,需要治疗
平时可以吃些花生衣,大枣,莲藕,猪皮,赤小豆等
高医生
继续阅读
- 暂无推荐
